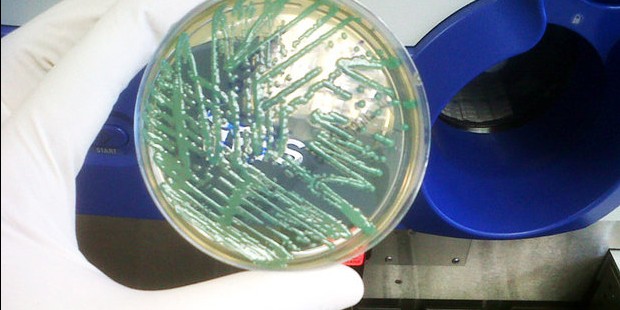

INFECÇÃO POR SUPERBACTERIA CAUSA MORTES NO DISTRITO FEDERAL
- 2.001
- 0
- redacao
Três pessoas que foram isoladas após contato com paciente com superbactéria morreram e outras 13 pessoas estão sendo monitoradas, de ...

.APÓS 5 MESES DE LUTA NA JUSTIÇA, MENINO CONSEGUE REMÉDIO À BASE DE MACONHA NO ACRE
- 2.840
- 0
- redacao
Após cinco meses lutando na Justiça, a família do menino Antônio Davi Manasfi, 3 anos, conseguiu o direito de receber ...

EJACULAÇÃO PRECOCE PODE SER COMBATIDA COM HIPNOSE CLÍNICA, AFIRMA ESPECIALISTA
- 3.063
- 0
- redacao
Conhecida condição sexual, a ejaculação precoce é mais comum em homens jovens e com pouca experiência sexual, mas se torna ...

ANS SUSPENDE 87 PLANOS DE SAÚDE, INCLUSIVE UNIMED ITABUNA
- 2.459
- 0
- redacao
A Agência Nacional de Saúde Suplementar (ANS) determinou desde o dia (18/05), a suspensão da venda de 87 ...

FIOCRUZ BAIANA CRIA TESTE RÁPIDO PARA VACINA CONTRA DOENÇA DO RATO
- 3.304
- 0
- redacao
Se depender dos esforços da unidade baiana da Fundação Oswaldo Cruz(Fiocruz), dentro de pouquíssimo tempo, centros de saúde de todo ...

UESC INTEGRA COMISSÃO PARA CONSTRUÇÃO DO CONSÓRCIO DE SAÚDE
- 4.303
- 0
- redacao
A Universidade Estadual de Santa Cruz - Uesc, representada pelo Pró-Reitor de Extensão, Alessandro Santana, oficializou, nesta quinta-feira, 7, o ...

AURELINO LEAL: VACINAÇÃO CONTRA GRIPE COMEÇOU E VAI ATÉ O DIA 22
- 3.761
- 0
- redacao
Até 22 de maio crianças de seis meses a menores de cinco anos, idosos com 60 anos ou mais, trabalhadores ...

CAMPANHA NACIONAL CONTRA GRIPE COMEÇA NESTA SEGUNDA FEIRA
- 3.415
- 0
- redacao
Começa nesta segunda-feira (4) a Campanha de Vacinação contra a Gripe em todo o país. Serão 65 mil postos de ...

APÓS REALIZAR EXAME, MULHER DESCOBRE QUE TEM DUAS VAGINAS
- 4.298
- 0
- redacao
A americana Cassandra Bankson, de 22 anos, famosa pelos tutoriais de maquiagem no YouTube, descobriu que tem duas vaginas ao ...

LIGA DO TRAUMA DA UESC REALIZA EVENTO ESTADUAL
- 3.476
- 0
- redacao
A Liga de Atendimento ao Trauma e Emergências da UESC estará realizando nos dias 15 e 16 de maio deste ...
